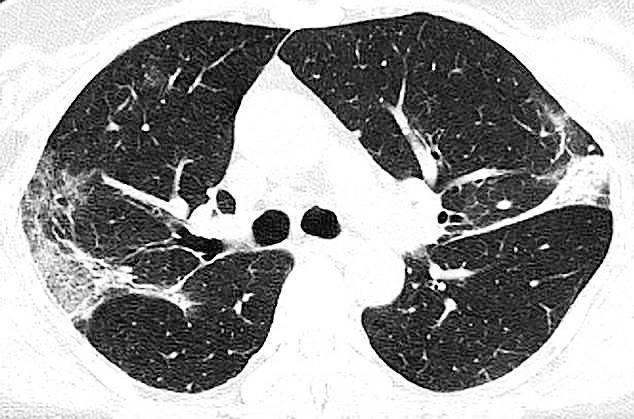
कोरोना मरीज के फेफड़े खराब कर देता है कोरोना, भर जाता है बलगम

कोरोना मरीज के फेफड़े खराब कर देता है कोरोना, भर जाता है बलगम
चीन के एक आदमी के फेफड़ों का एक्स-रे किया गया है. इसमें जो तस्वीरें सामने आईं हैं वो बेहद भयानक है. इसमें साफ-साफ दिख रहा है कि कैसे कोरोना वायरस फेफड़ों में घुसकर सांसों को रोकने लगता है. ब्लैक एंड व्हाइट एक्स-रे में आपको ढेर सारे सफेद चकत्ते दिखाई देंगे. एक्स-रे में दिख रहे यही स्पॉट कोरोना वायरस से प्रभावित हिस्सा हैं. यहां बलगम (Mucus) बन रहा है. (फोटोः RSNA)
एक्स-रे को देखने वाले रेडियोलॉजिस्ट इस सफेद चकत्ते को ग्लास ओपेसिटी कहते हैं. यानी फेफड़े में जिस जगह हवा होनी चाहिए, वहां पर कोरोना वायरस विकसित हो चुका है. वह उस स्थान पर बलगम बना रहा है. इसकी वजह से लोगों को सांस लेने में दिक्कत होने लगती है. जिस व्यक्ति का एक्स-रे सामने आया है वह वुहान के मांस बाजार से संक्रमित हुआ था. (फोटोः RSNA)
दुनियाभर के डॉक्टरों को कोरोना वायरस मरीजों के एक्स-रे और सीटी स्कैन में ऐसे ही सफेद चकत्ते देखने को मिल रहे हैं. ये सार्स और मर्स जैसी बीमारियों के एक्स-रे से मिलते-जुलते हैं. डॉक्टरों का कहना है कि कोरोना वायरस का एक्स-रे सार्स और मर्स के एक्स-रे की तुलना में ज्यादा भयावह हैं. रेडियोलॉजिस्ट को कोरोना के सभी मरीजों के एक्स-रे और सीटी स्कैन में ग्लास ओपेसिटी ज्यादा देखने को मिल रही है. (फोटोः RSNA)
Advertisement
ये तस्वीरें रेडियोलॉजिकल सोसाइटी ऑफ नॉर्थ अमेरिका (RSNA) द्वारा जारी की गई हैं. सोसाइटी ने करीब 1000 मरीजों की जांच की है. सभी की छाती का एक्स-रे और सीटी स्कैन किया गया है. इसके बाद सभी के एक्स-रे और सीटी स्कैन में समानता खोजी गई. तब जाकर पता चला कि आखिर कोरोना मरीज के फेफड़ों में सफेद चकत्ते कितने भयावह हैं. (फोटोः RSNA)
Chest CT outperformed lab testing in the diagnosis of 2019 novel #coronavirus disease (#COVID19), according to a study of more than 1,000 patients just published in @radiology_rsna: https://t.co/JoObdXPNbx #CoronavirusOutbreak pic.twitter.com/Ak5n4XL9GQ
— RSNA (@RSNA) February 26, 2020
वुहान की ही एक 54 वर्षीय महिला के फेफड़ों का सीटी स्कैन किया गया. इसमें भी ग्लास ओपेसिटी पाई गई. इस महिला को कोविड-19 की वजह से भयानक स्तर का निमोनिया हो गया था. इस महिला को सांस लेने में इतनी ज्यादा दिक्कत हो रही थी कि उसे ऑक्सीजन देना पड़ रहा था. (फोटोः RSNA)
सार्स की वजह से नवंबर 2002 से जुलाई 2003 तक करीब 8000 लोग बीमार हुए थे. इनमें 774 लोगों की मौत हो गई थी. इन सभी के फेफड़ों का एक्स-रे और सीटी स्कैन एक जैसा था. सभी के एक्स-रे और स्कैन में फेफड़े के बीच सफेद चकत्ते मिले थे. कोरोना वायरस की वजह से सभी की छाती में म्यूकस बन रहा था.
Advertisement